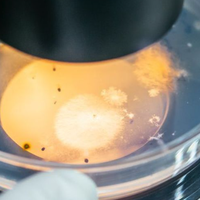
microscopic

Education
Virtual Work Experience
Connect classroom learning to
real-world careers with our
interactive programmes
AI Tools
Sponsors
Partners
Company
Viewing Education section
Switch to CareersEducation
Virtual Work Experience
Connect classroom learning to
real-world careers with our
interactive programmes